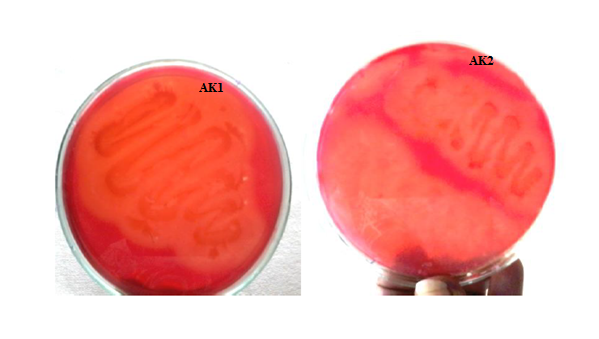

1Department of Biotechnology, M. M. E. S Women’s Arts and Science College, Melvisharam, Vellore 632509, 2Department of Biotechnology, Dhanabagiyam Krishnaswamy Mudaliar College for Women, Sainathapuram, Vellore 632001
Email: madhusudhan.archana@gmail.com
Received: 06 Apr 2016 Revised and Accepted: 21 Jun 2016
ABSTRACT
Objective: The infestation of water hyacinth in the aquatic system produces serious environmental problems. In our study, we have used the water hyacinth as a substrate for the production of cellulase enzyme from bacteria isolated from decayed water hyacinth.
Methods: The bacterial isolates were morphologically and biochemically characterized and the bacterial cultures were identified as Proteus vulgaris and Serratia ficaria respectively. The effect of various process parameters such as pH, temperature, substrate concentration and fermentation time on cellulase production by Proteus vulgaris were optimized.
Results: Out of twenty five isolates, two bacteria viz. AK1 and AK2 grew well on CMC agar media. Cellulase enzyme activity was found to be higher (4.07 U/ml) in case of Proteus vulgaris compared to Serratia ficaria. Cellulase production by Proteus vulgaris was optimized as pH 7, 35 °C temperature, 30% of water hyacinth and 24 h of incubation time. Cellulase produced under optimum condition was purified using dialysis and ion exchange chromatography. The molecular weight and specific activity of completely purified cellulase was found to be 33 KDa and 361.25 U/mg respectively.
Conclusion: It can be concluded that the water hyacinth can be used as a potential substrate for production of cellulase by Proteus vulgaris which is isolated from decayed water hyacinth.
Keywords: Water hyacinth, Cellulase, Solid state fermentation, Optimization, Purification
© 2016 The Authors. Published by Innovare Academic Sciences Pvt Ltd. This is an open access article under the CC BY license (http://creativecommons. org/licenses/by/4. 0/)
INTRODUCTION
Water hyacinth (Eichhornia crassipes) is a free-floating perennial plant that can grow to a height of three feet. The dark green leave blades are circular to elliptical in shape attached to a spongy, inflated petiole and the root system is thick, heavily branched and dark fibrous which is present underneath the water. It has striking light blue to violet flowers located on a terminal spike. Water hyacinth is considered as world’s worst invasive aquatic plant which causes serious environmental problems. Excessive growth can result in complete coverage of water surfaces, which degraded natural habitats in several ways. Heavy growth of these aggressive weeds competes with and shades desirable native vegetation. Mats of floating plants prevent atmospheric oxygen from entering the water while decaying plants drop to the bottom, greatly consuming dissolved oxygen needed by fish and other aquatic life. A number of physicochemical and biological methods have been devised to control the growth and spread of these aquatic weeds. But these methods have failed to control the infestation of water hyacinth in water bodies. As an alternative to these techniques, a concept called “Eradication through utilization” is being adopted by many countries [1, 2].
In this perspective, water hyacinth can be eradicated by utilizing it as a natural source for production of various commercially important products. Cellulases are inducible enzymes which are synthesized by a large number of microorganisms either cell bound-or extracellular during their growth on cellulosic materials [3]. They have attracted much interest because of the diversity of their application. The major industrial applications of cellulases are in the textile industry for “bio-polishing of fabrics and producing stonewashed look of denims, as well as in household laundry detergents for improving fabrics softness and brightness [4]. It is used in the fermentation of biomass into biofuels [5]. The cost of production of cellulase by solid state fermentation using different substrates such as solka floc, avicel or sulphite pulp are extremely expensive and contribute around 48-52% to the overall cost of cellulase production. In addition to high cost, the use of pure chemicals in cellulase production coupled with low enzyme activities limits its industrial use [6]. As an alternative to chemical substrates, naturally available lignocellulosic substrates can be effectively utilized for production of cellulase.
Cellulase could be produced by many lignocellulosic feed stocks such as straws, bagasse, wheat bran, corn stover and corncob etc. From the review of literature, it is clear that no research work have been carried out using water hyacinth as substrate for production of bacterial cellulase. Water hyacinth has following composition, lignin content (3.50%) and hemicellulose (48.70%), cellulose (18.20%) and crude protein (13.30%) and thus could serve as promising substrate for cellulase production. Our study focuses on the production of bacterial cellulase using water hyacinth substrate, whose growth and spread need to be controlled or eradicated from the environment.
The objectives of present investigation were i) isolation, screening and identification of cellulolytic bacteria from decayed water hyacinth ii) production and optimization of conditions such as pH, temperature, substrate concentration and fermentation time on cellulase production iii) purification of crude enzyme by dialysis and ion exchange chromatography iv) determination of molecular weight of the enzyme by SDS-PAGE and v) estimation of protein content and specific activity of enzyme samples.
MATERIALS AND METHODS
Isolation of cellulolytic bacteria from water hyacinth [7]
Decayed water hyacinth plants were collected from ponds in and around Vellore, Tamil Nadu, India. 10 g of decayed plants were taken in a sterile bottle containing 100 ml of 0.8% NaCl. The mixture was shaken for 1 hour on a rotary shaker at 250 rpm to dispense the samples. These samples were diluted and spread plated on a nutrient agar. The plates were incubated for 48 h at 37 °C [7].
Screening of cellulase producing bacteria [8]
Carboxy methyl cellulose (CMC) agar medium with 1% of cellulose was prepared and sterilized. To the prepared medium a loopful of isolated cultures were streaked and incubated at 37 °C for 2 d. After incubation, the plates were flooded with an aqueous solution of Congo red (1% w/v) for 15 min. The plates were then observed for the zone of hydrolysis. Congo Red solution was then poured off and the plates were further flooded with 1N NaCl for 15 min. Clear zones around the colonies on CMC agar indicated cellulase activity. The diameters of clear zones around the colonies were measured in centimeter. The isolates producing larger zones were selected for further studies and subcultured on nutrient agar. The experiments were performed in triplicates [8].
Identification of bacterial isolates by morphological and biochemical analysis [9, 10]
For bacterial identification, Gram staining and biochemical tests such as indole, methyl red and Voges-Proskauer, citrate utilization, urease, oxidase, catalase, carbohydrate fermentation tests were performed [9, 10].
Production of cellulase by solid state fermentation on water hyacinth [11]
10 g of fresh water hyacinth (Eichhornia crassipe), collected from ponds near Katpadi railway station, Vellore, India was chopped into pieces and used as a substrate for cellulase production. The chopped plant was taken in 100 ml of minimal media containing flask. The flasks were autoclaved for 15 min. After cooling, the flask was inoculated with 1 ml of overnight culture of bacterial isolate selected for the investigation [11].
Cellulase assay
The fermented media were filtered through dampened cheese cloth after 24 h of incubation. The filtrate was collected and centrifuged at 10,000 rpm at 4 °C for 15 min. The supernatant was used as crude enzyme. Cellulase enzyme activity was assayed using Dinitrosalisic acid (DNS) reagent [12] by estimating the reducing sugars released from CMC. Crude enzyme was added to 0.5 ml of 1 % CMC in 0.05 M phosphate buffer and incubated at 50 °C for 30 min. After incubation, the reaction was stopped by the addition of 1.5 ml of DNS reagent and boiled at 100 °C in water bath for 10 min. Sugars liberated were determined by measuring absorbance at 540 nm. Cellulase production was estimated by using glucose calibration curve [13]. One unit (U) of enzyme activity is expressed as the quantity of enzyme, which is required to release 1 mol of glucose per minute under standard assay conditions [14].
Optimization of conditions for cellulase production
To optimize the fermentation conditions, the fermentation were carried out at different pH (5, 6, 7, 8 and 9), temperature (30, 35, 40, 45 ° C), incubation time (24, 48, 72, 96, 120, 144 and 168 h) and substrate concentration (10% to 60%). The volume of fermentation media was 100 ml for each experiment. The experiments were done in triplicates and mean values are reported. The cellulase activity under the above mentioned conditions was measured using standard dinitro-salicylic acid (DNS) method mentioned above.
Purification of cellulase enzyme [15]
Dialysis
The crude enzyme produced under optimized conditions was loaded into the dialysis tube using a sterile pipette. The sample was dialyzed in phosphate buffer for 1-2 h at room temperature. The buffer was removed and fresh dialysis buffer was added and the sample was dialyzed for another 1-2 h. The buffer was discarded and again fresh dialysis buffer was added and the dialysis was performed overnight at 4 °C. The dialysis buffer was changed and dialysis was performed for another 1 to 2 h [15].
Ion exchange chromatography
The dialyzed sample was subjected to ion exchange chromatography. SP-Sepharose ion exchange column was used for the enzyme purification. The column was run using 50 mM phosphate buffer at pH 7.0. The cellulase enzyme was eluted with different NaCl strength ranging from 25-500 mM. Fractions (5 ml) were collected at a flow rate of 30 ml/hr. The O. D values of eluted samples were measured at 280 nm for the presence of protein. The eluted samples were assayed for enzyme activity.
Determination of molecular weight of purified cellulase using SDS-PAGE [16]
Purified cellulase was subjected to SDS-PAGE analysis to determine the molecular weight [16]. It was carried out in such a way that the standard protein marker was loaded in first lane, followed by crude enzyme in second lane, in the third lane dialyzed sample was loaded, in the fourth to seventh lane samples eluted at different NaCl strength in ion exchange chromatography was loaded. The silver staining was performed to visualize separated proteins.
Estimation of protein and specific activity of enzyme samples
The amount of protein present in the enzyme samples (crude extract, dialyzed sample and eluted sample from ion exchange chromatography) were determined using Lowry’s method [17]. To 0.8 ml of enzyme sample, 2 ml of alkaline copper tartrate was added and incubated at room temperature for 10 min. Then 0.2 ml of Folin ciocalteau reagent was added and vortexed. The sample absorbance was read at 620 nm in UV-Visible Spectrophotometer. Standard graph was constructed using different concentration of Bovine Serum Albumin. Specific activity of enzyme is defined as the activity of enzyme per mg of total protein present in the enzyme. For the entire enzyme samples specific activity was measured.
RESULTS AND DISCUSSION
Isolation, screening and identification of cellulolytic bacteria from water hyacinth
Twenty five distinct colonies of bacteria were isolated from decayed water hyacinth. Among twenty five isolated bacteria, ten bacteria grew on CMC-containing medium under aerobic condition at 37 °C. The bacterial isolates were screened for cellulase production. Out of ten, two bacterial cultures viz. AK1 and AK2 showed significant clear zones (23 mm and 18 mm) around the colonies when the culture plates were flooded with congo red, which indicated that the bacteria were capable of degrading cellulose effectively and utilized it as a carbon source (fig. 1).
Fig. 1: Bacterial isolates AK1 and AK2 show clear zones around the colonies
These two bacterial isolates were identified and selected for further investigation. Table 1 shows the results of morphological and biochemical tests performed with AK1 and AK2. Using Bergey’s Manual, the bacterial isolates AK1 and AK2 were identified as Proteus vulgaris and Serratia ficaria respectively.
Production of cellulase by solid state fermentation on water hyacinth
Production of cellulase by two bacteria viz. Proteus vulgaris and Serratia ficaria using water hyacinth as substrate were performed in duplicates. Among two bacteria, Proteus vulgaris showed maximum CMCase activity of 4.07U/ml compared to that of Serratia ficaria (2.2 U/ml) and Proteus vulgaris was selected for further investigation.
Table 1: Morphological and biochemical characteristics of bacterial isolates
| Characteristics | AK1 | AK2 |
| Gram Stain | + | + |
| Motility test | + | + |
| Indole test | + | - |
| Methyl Red (MR) test | + | - |
| Voges-Proskauer (VP) test | - | - |
| Citrate test | + | + |
| Urease test | + | - |
| Oxidase test | + | + |
| Catalase test | + | - |
| Sugar Fermentation | ||
| Glucose | Acid and Gas formation | Acid and No Gas formation |
| Fructose | Acid and Gas formation | Acid and Gas formation |
| Maltose | No Acid and No Gas formation | Acid and Gas formation |
| Sucrose | Acid and No Gas formation | Acid and No Gas formation |
| Lactose | Acid and No Gas formation | No Acid and No Gas formation |
| Starch | Acid and Gas formation | No Acid and Gas formation |
Optimization of conditions for cellulase production
Effect of pH on cellulase production
pH plays a major role in activity of any enzyme. Experiments were carried out to optimize the pH for enzyme activity at different pH ranging from 4 to 8. On increasing the pH from 4 to 7, the enzyme activity increased from 1.3 to 4.07 U/ml and on further increase in pH to 8, the enzyme activity decreased to 1.9 U/ml (fig. 2). The optimal initial pH for cellulase production by Bacillus isolated from artificial manure was reported as 6.0 by [18]. On controversy, Acharya and Chaudhary [19] found that B. subtilis isolated from a hot spring showed maximum cellulase activity at pH 9.0.

Fig. 2: Effect of pH on cellulase production by bacteria on water hyacinth substrate
The results were expressed as mean±SEM; n=3
Effect of temperature on cellulase production
Temperature also has a significant effect on enzyme activity. Increase in temperature from 30 to 35 °C showed an increase in enzyme activity from 4.07 to 9.23 U/ml (fig. 3). On further increase, the enzyme activity decreased due to denaturation of the enzyme at a higher temperature. However, Sheikh et al. [20] observed that the enzyme activity of Bacillus sp. was gradually increased with the increase in temperature and the highest cellulase activity was found to be 3.5U/ml at 50 °C.
Effect of substrate concentration on cellulase production
In the present study, different concentrations of water hyacinth (0.1 mg/ml to 0.6 mg/ml) were examined to study their effects on cellulase production. The results showed that maximum enzyme activity was observed as 25.35 U/ml when 30% of water hyacinth was used as carbon and nitrogen source (fig. 4). Yang et al. [21] reported the maximum CMCase activity (2.91U/ml) was observed when a mixture of 1% corn powder and 1%CMC was used as the sole carbon source for Bacillus subtilis isolated from Tibetan Pig’s intestine.

Fig. 3: Effect of temperature on cellulase production by bacteria on water hyacinth substrate
The results were expressed as mean±SEM; n=3

Fig. 4: Effect of substrate concentration on cellulase production by bacteria on water hyacinth substrate
The results were expressed as mean±SEM; n=3
Effect of fermentation time on cellulase production
The CMCase activity was measured at various fermentation times (24, 48, 72, 96, 120, 144, 168 h) under optimized pH, temperature and substrate concentration. The results showed considerable variation in cellulase production at different times. The strain grew vigorously and the cellulase yield was high when the fermentation time was 24 h (fig. 5). Good CMCase activity (25.35 U/ml) was observed at 24 h cultivation, but it decreased continuously during the time from 24 h to 168 h. Similar results were obtained by Yang et al. [21]. They reported that Bacillus subtilis isolated from Tibetan Pig’s intestine showed maximum CMCase activity at 24 h of cultivation.

Fig. 5: Effect of fermentation time on cellulase production by bacteria on water hyacinth substrate
The results were expressed as mean±SEM; n=3
Purification of cellulase enzyme by dialysis and ion exchange chromatography
Partial Purification of enzyme was carried out by dialysis which is followed by ion exchange chromatography. Dialysed enzyme activity was found to be 32.35 U/ml. Enzymes eluted from ion exchange chromatography using different NaCl strength (25-500 mM) were assayed. Highest enzyme activity (43.25 U/ml) was observed when NaCl strength of 150 mM was used.
Molecular weight determination
SDS PAGE was carried out in order to determine the molecular weight of crude enzyme, dialysed enzyme and enzyme purified using ion exchange chromatography. Fig. 6 shows the separation of enzyme samples on SDS PAGE gel. Comparing the bands of molecular weight marker, with the bands of enzyme samples, the molecular weights of enzyme samples were determined as 33 KDa for all enzyme samples.

Fig. 6: Separation of enzyme samples on SDS PAGE gel, first lane-standard protein marker, second lane-crude enzyme, third lane-dialyzed sample, fourth to seventh lane-samples eluted at different NaCl strength (25 to 500 mM) in ion exchange chromatography
Estimation of protein and specific activity of enzyme samples The protein content of the crude enzyme, dialysed enzyme and enzyme purified using ion exchange chromatography were determined as 0.4, 0.25 and 0.12 mg/ml using Lowry’s method. Bovine serum Albumin was used as a standard. The specific activities of the crude enzyme dialyzed enzyme and enzyme eluted through ion exchange chromatography were 62.5 U/mg, 129.40 U/mg and 361.25 U/mg. It is evident from the results that enzymes purified through ion exchange chromatography showed highest specific activity compared to other enzyme samples.
CONCLUSION
Water hyacinth (Eichhornia crassipes) is a widely prevalent aquatic weed in India. This most damaging water weed blocks waterways, affecting both navigation and drainage and increases siltation and flooding. The high content of hemicellulose (30–55% of dry weight) in water hyacinth can provide hemicellulosic sugars for the production of cellulase enzyme, which has widespread application in textile, food, detergent, leather and paper industries. It is also used in fermentation industry where the spent cellulosic biomasses are converted into bioethanol. The present study focuses on the eradication of water hyacinth through its utilization to produce cellulase enzyme. Proteus vulgaris isolated from water hyacinth showed maximum clear zone on CMC agar media when flooded with congo red. For improving the cellulase production by Proteus vulgaris on water hyacinth, various process parameters viz. pH, temperature, substrate concentration and fermentation time were optimized. Cellulase produced under optimum condition was purified using dialysis and ion exchange chromatography. The purified enzyme samples were run on SDS PAGE and the molecular weight of cellulase enzyme was determined as 33 KDa. It can be concluded that the water hyacinth can be used as a potential substrate for production of cellulase by Proteus vulgaris which is isolated from decayed water hyacinth.
ACKNOWLEDGEMENT
The authors thank the Department of Biotechnology, Dhanabagiyam Krishnaswamy Mudaliar College for Women, Sainathapuram,Vellore for providing the laboratory facilities to carry out the research work. The authors are also grateful to the Management of M. M. E. S Women’s Arts and Science College for their encouragement to publish this research work.
CONFLICT OF INTERESTS
Declared none
REFERENCES
How to cite this article